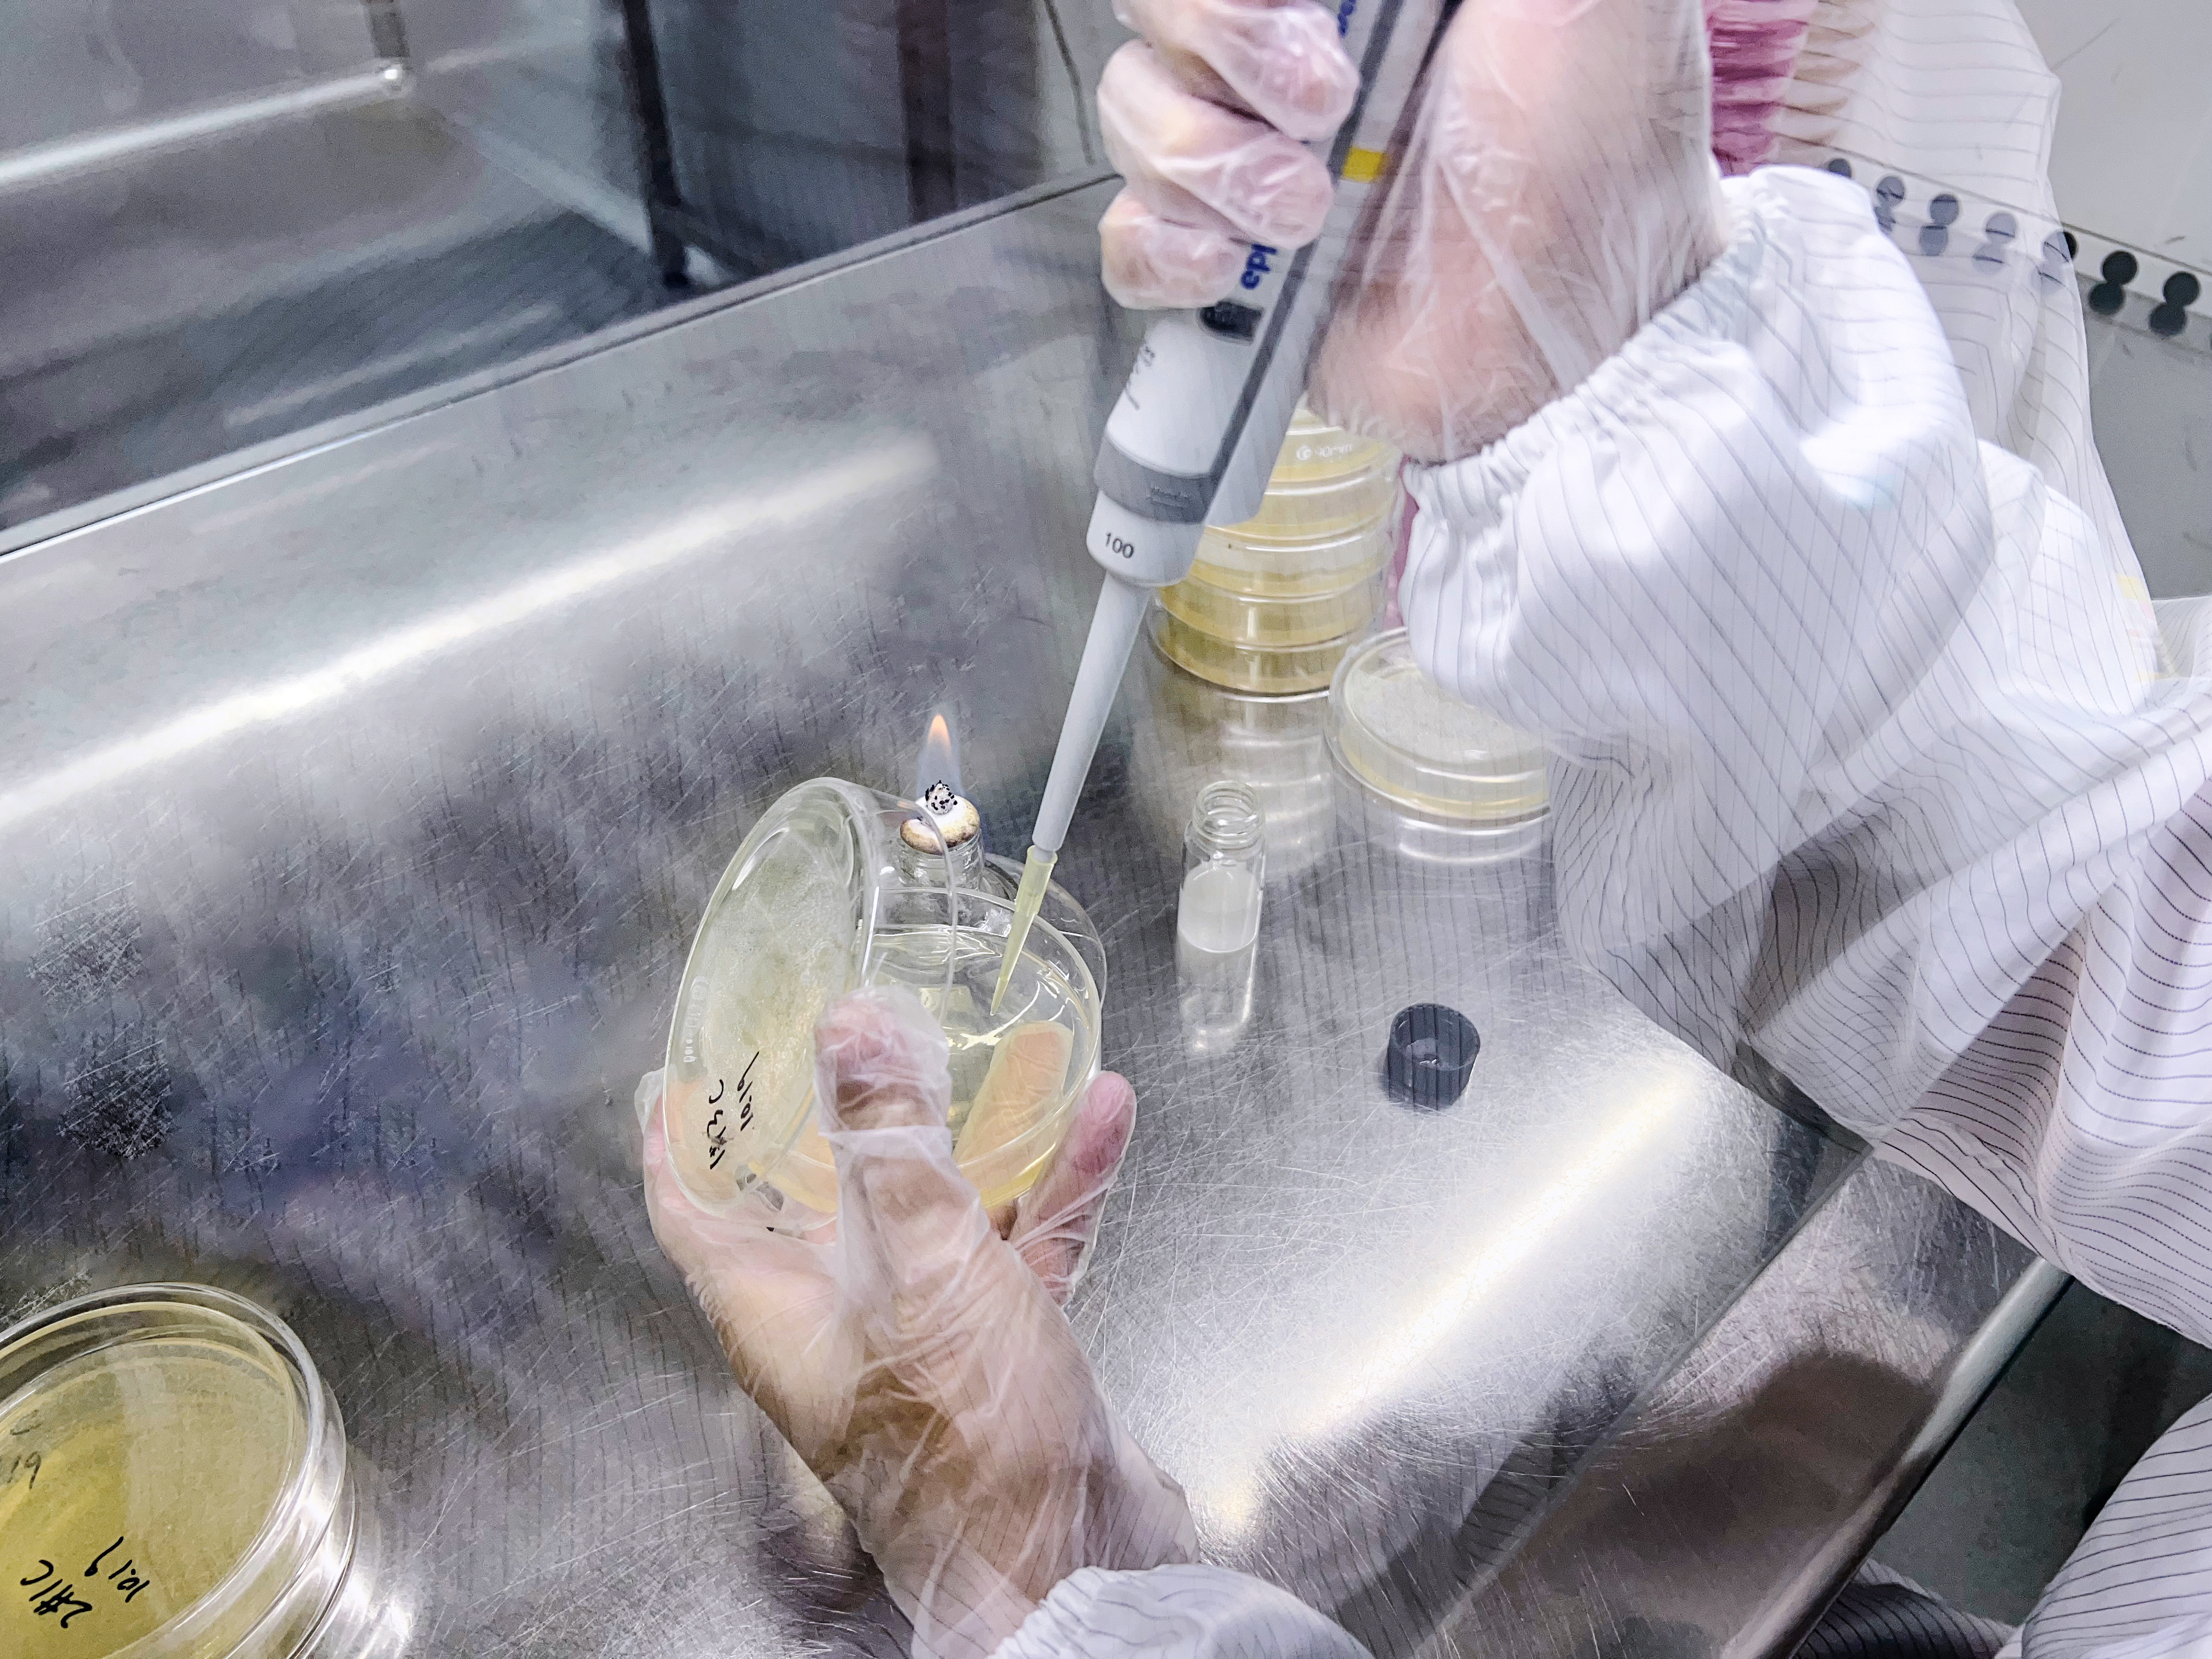

導語:在2021年國家化妝品監督抽檢工作中,50批次化妝品不符合規定的通告,其中不乏存在微生物超標的情況。
各國對化妝品防腐劑的使用均有相關規定,防腐劑的添加量也有嚴格規定,不允許超量使用。因此,配方設計時,防腐體系的構建是配方工程師必須考慮的問題。廣義的防腐劑包括抑菌劑、殺菌劑、抗氧化劑以及食鹽、辛香料等物質。下文以“抗(抑)菌產品”代指防腐劑、抑菌劑。

要確保化妝品有足夠的抗二次污染能力,產品中需要添加一定劑量的抗(抑)菌產品,確定合適的劑量,則涉及到一個概念:抗(抑)菌產品的最小抑菌濃度。抗(抑)菌產品的抑菌效率以最小抑菌濃度(Minimal Inhibitory Concentration,MIC)來表示,簡稱MIC。
MIC定義
能夠抑制細菌生長、繁殖的最低藥物濃度即最小抑菌濃度。MIC測試適用于
測定出一個物質的最低抑菌濃度,用以評價該物質的抑菌能力。參考試驗得到最小抑菌濃度,為實際生產添加用量提供理論依據。
MIC方法簡介
Introduction to MIC Method
MIC測試方法有很多種,根據化妝品抗(抑)菌產品類型及參考消毒技術規范2002,常見的測試方法有如下三種:瓊脂稀釋法、常量肉湯稀釋法、微量肉湯稀釋法(96孔板法)
01瓊脂稀釋法* 本方法適用于不溶性抗(抑)菌產品
原理:是將不同劑量的抗(抑)菌產品,加入融化并冷至50℃左右的定量MH瓊脂中,制成含不同遞減濃度抗(抑)菌產品的平板,接種受試菌,孵育后觀察細菌生長情況,以抑制細菌生長的瓊脂平板所含最低藥物濃度為MIC。優點:可在一個平板上同時作多株菌MIC測定,結果可靠,易發現污染菌。缺點:制備含抗(抑)菌產品的瓊脂平板費時費力。
02常量肉湯稀釋法* 本方法適用于可溶性抗(抑)菌產品
原理:本試驗將不同濃度的抑菌劑混合溶解于營養肉湯培養基中,然后接種細菌,通過細菌的生長與否,確定抗(抑)菌產品抑制受試菌生長的最低濃度,即最小抑菌濃度。優點:通過觀察培養基是否渾濁較直觀判定測試樣品對特定菌種的MIC值。缺點:只能測試水溶性好且清澈透明的樣品,而且肉眼觀察有一定的誤差。
03微量肉湯稀釋法(96孔板法)* 主要適用于需氧菌及局部兼性厭氧菌
原理:將倍比稀釋后不同濃度的抗(抑)菌產品溶液分別加到滅菌的96孔聚苯乙烯板中,第1至第11孔加樣液,每孔10μl,第12孔不加樣作為生長對照,冰凍干燥后密封,-20℃以下保存備用。接種物制備將用生長法或直接菌懸液法制備的濃度相當于0.5麥氏比濁標準的菌懸液,經 MH肉湯1:1000稀釋后,向每孔中加100μl,密封后置35℃普通空氣孵箱中,孵育16~20h判斷結果。
優點:能夠更準確的得到細菌對某種抗(抑)菌產品的MIC值。缺點:操作較為繁瑣。總結
summary
抗(抑)菌產品的MIC由試驗方法求得,MIC越小抑菌活性越大,且同一抗(抑)菌產品對不同菌種有不同的MIC。理論上來說,抗(抑)菌產品添加量越高則抑菌效率越高,而實際上,我國對化妝品準用防腐劑和用量均有明確限制。
如何在法規允許的前提下,建立一整套更加安全、溫和的防腐抑菌解決方案?既要保證化妝品的抑菌性能,又要避免因防腐劑引起的對人體產生的刺激性、易過敏等副作用?答案便是:基于安全成分建立新型的防腐抑菌解決方案。
在建立過程中,需要考慮不同抗(抑)菌產品的作用機制以及化妝品配方的劑型、成分等因素,通過復配的方式降低各抗(抑)菌產品單體的使用量,拓寬抗菌譜,提高抑菌效果,預防微生物耐藥性的產生。
如需了解更多產品的防腐抑菌解決方案,可以關注公眾號進行留言!

復制